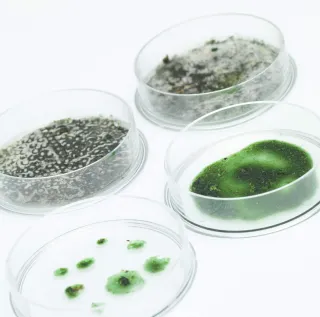

Szybka i kompleksowa diagnostyka alergii
295 alergenów w jednym teście
Test alergiczny ALEX
Wielokierunkowa i precyzyjna diagnostyka alergii
Test alergiczny ALEX 295 zawiera wszystkie istotne źródła uczulenia, zapewnia diagnostykę dla ponad 99% najczęściej występujących alergii, między innymi takich jak:
Test alergiczny ALEX - dlaczego warto?
Większość pacjentów z alergią wykazuje dodatnie wyniki badań dla wielu alergenów i prawdziwy czynnik wywołujący objawy może być trudny do identyfikacji. Test na alergię ALEX Panel 295 pozwala precyzyjnie ustalić właściwą cząstkę uczulającą.
Najszerszy panel 295 alergenów
117 ekstraktów oraz 178 molekuł.
Indywidualny profil uczuleniowy
Bez odstawiania leków.
Dla osób w każdym wieku
Od niemowląt po osoby starsze.
Jednorazowe pobranie krwi
Niewielka ilość materiału do analizy. Tylko 0.1 mililitra.
Tylko w teście ALEX
40 alergenów
Nanotechnologia
Inowacyjna technologia testu.

Test alergiczny
Alergia to częsty problem, który obniża komfort życia. Katar, kichanie, pokrzywka, bóle brzucha i biegunka – te i inne objawy mogą być wynikiem reakcji alergicznej organizmu. Testy skórne nie zawsze przynoszą odpowiedzi. Gdy popularne testy alergiczne nie pozwoliły ustalić, co uczula, a leczenie okazało się nieskuteczne, z pomocą przychodzi diagnostyka molekularna alergii. A wraz z nią - test ALEX Panel 295.
Test ALEX – 295 alergenów w jednym badaniu
ALEX Panel 295 to immunoenzymatyczny test z krwi do diagnostyki komponentowej alergii IgE – zależnej. Badanie pozwala na ocenę IgE wobec aż 295 składowych (117 ekstraktów i 178 molekuł). Wśród badanych alergenów znajdują się m.in. pyłki roślin, jady owadów, alergeny zwierząt domowych, drożdże i pleśnie, alergeny pokarmowe. Test ALEX umożliwia też wykrycie uczulenia na lateks.
Test alergiczny ALEX Panel 295 pozwala na precyzyjną identyfikację cząstki uczulającej, co jest podstawą do opracowania skutecznego leczenia i poprawę jakości życia. Badanie jest wykonywane z krwi i nie wymaga specjalnego przygotowania - jest odpowiednie zarówno dorosłych, jak i dzieci.